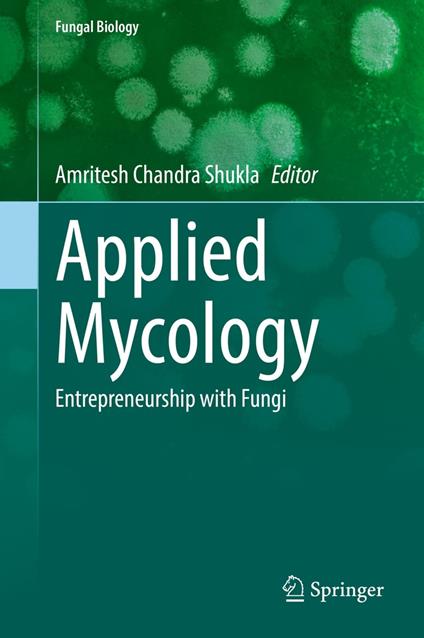
Applied Mycology

L’articolo è stato aggiunto alla lista dei desideri
IBS.it, l'altro eCommerce
Applied Mycology
Cliccando su “Conferma” dichiari che il contenuto da te inserito è conforme alle Condizioni Generali d’Uso del Sito ed alle Linee Guida sui Contenuti Vietati. Puoi rileggere e modificare e successivamente confermare il tuo contenuto. Tra poche ore lo troverai online (in caso contrario verifica la conformità del contenuto alle policy del Sito).
Grazie per la tua recensione!
Tra poche ore la vedrai online (in caso contrario verifica la conformità del testo alle nostre linee guida). Dopo la pubblicazione per te +4 punti
Prezzo minimo ultimi 30 giorni: 204,97 €
Altre offerte vendute e spedite dai nostri venditori



Tutti i formati ed edizioni
Promo attive (0)
Fungi are an important link in the food webs of all ecosystems. They have immense potential and comprise a myriad of useful bioactive compounds. Fungi feature in a wide range of diverse processes and applications in modern agriculture, the food science industry, and the pharmaceutical industry. In the food and drink arena, the role of fungi is historically important in the form of mushrooms and in fermented foods as yeasts for baking and brewing. These roles are supplemented by the use of fungal food processing enzymes and additives, and more recently in the development of protein-based foodstuffs from fungi. Additionally, they are used in the formulation of biofertilizers and biopesticides used as biostimulants and bioprotectants of crops. The practical use of newer techniques such as genetic recombination and robotics have revolutionized the modem agricultural biotechnology industry, and have created an enormous range of possible further applications of fungal products. Myco-materials created from mycelia (the root-like parts of fungi) are gaining attention as a sustainable alternative for a wide range of materials. They are being used as insulation, sustainable packaging, foam inserts, and even "eco-leather.” In fact, mycelium bricks are pound-for-pound stronger than concrete. In addition, medicinal uses of fungal species have been historically recorded as important agents in the pharmaceutical sciences. The potential for myco-materials seems limitless. The field of mycology and its application has become an increasingly important component in the education of industrial biotechnology. This book on applied mycology provides information helpful for developing entrepreneurial opportunities with fungi. This volume explains both the basic science and the applications of mycology and bio-resource technology with special emphasis on entrepreneurial applications. It offers a complete, one-stop resource for those interested in microbiology, food and agricultural science, medical mycology, and for those in industrial biotechnology.
L'articolo è stato aggiunto al carrello
Formato:
Gli eBook venduti da IBS.it sono in formato ePub e possono essere protetti da Adobe DRM. In caso di download di un file protetto da DRM si otterrà un file in formato .acs, (Adobe Content Server Message), che dovrà essere aperto tramite Adobe Digital Editions e autorizzato tramite un account Adobe, prima di poter essere letto su pc o trasferito su dispositivi compatibili.
Cloud:
Gli eBook venduti da IBS.it sono sincronizzati automaticamente su tutti i client di lettura Kobo successivamente all’acquisto. Grazie al Cloud Kobo i progressi di lettura, le note, le evidenziazioni vengono salvati e sincronizzati automaticamente su tutti i dispositivi e le APP di lettura Kobo utilizzati per la lettura.
Clicca qui per sapere come scaricare gli ebook utilizzando un pc con sistema operativo Windows
L’articolo è stato aggiunto alla lista dei desideri